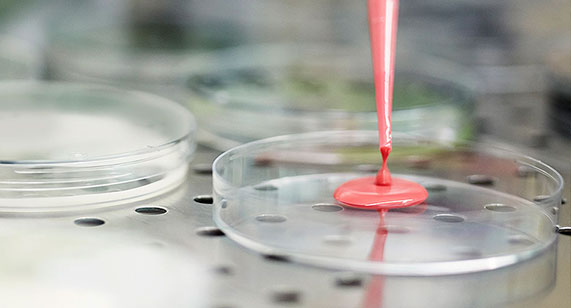
purple-pill-image

Projetadas para terem alto desempenho
As cápsulas e os equipamentos da Qualicaps são projetados
e fabricados tendo funcionalidade e
precisão em mente.
Cápsulas
Cápsulas duras: por mais de um século é a dosagem oral de preferência entre os fabricantes da indústria farmacêutica.

Maquinário
confiável para atender às necessidades dos mercados farmacêutico e nutracêutico.

EQUIPE CIENTÍFICA
Construindo um futuro saudável com parcerias ao longo do ciclo de vida do produto.

Trabalhe conosco
PROMOVENDO HÁBITOS SAUDÁVEIS ENTRE OS FUNCIONÁRIOS E COLABORANDO COM NOSSAS COMUNIDADES

NEWS & EVENTS
24 / 10 / 2023
A Roquette conclui a aquisição da Qualicaps.
A Roquette conclui a aquisição da Qualicaps e reforça sua posição global no setor farmacêutico. Esse investimento estratégico permitirá a criação de um líder mais forte, com uma ampla presença global, bem como uma rica oferta em soluções de dosagem oral.
Know-how
Acesse nossa biblioteca completa e encontre informações úteis e interessantes do ponto de vista comercial, científico e técnico, sobre cápsulas e equipamentos.







